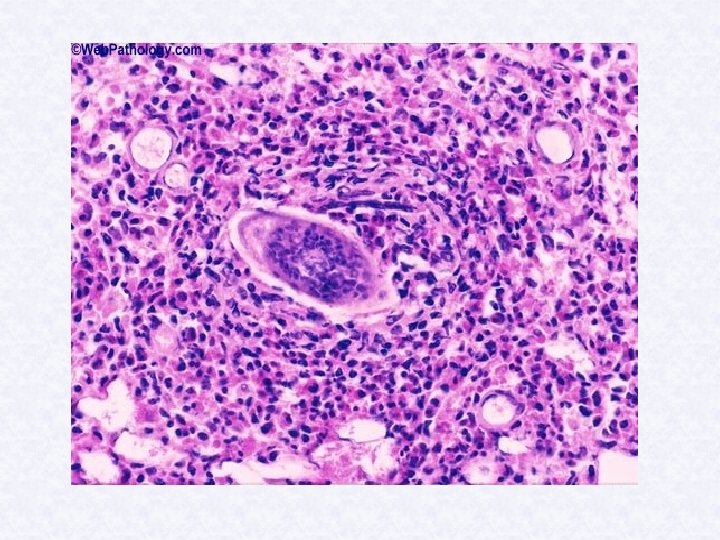

Remember Autoinfection Mode of infection Infective stage Definitive


• • • Remember Autoinfection Mode of infection Infective stage Definitive host Intermediate host • • Type of parasites Source of infection Vector transmission

Location in humans Trematodes (flukes) Blood Schistosoma hematobium S. mansoni S. japonicum S. mekongi s. intercalatum Liver Clonorchis sinensis Dicrocoelium dendriticum Opisthorchis felineus O. Viverrini Fasciola hepatica f. gigantica Intestine Fasciolopsis buski Echinostoma spp Heterophyes heterophyes lung Paragonimus westermani







Infective stage Forked tail cercaria Diagnostic stage Egg with lateral spine


Biomephlaria intermeddiat host



Schistosoma mansoni • Is caused by persons passing faces • containing eggs of parasite into water which is used for bathing , washing clothes , fishing …. After mating , mature S. mansoni flukes migrate to small tributary veins of inferior mesenteric, Which drain large intestine. flukes can also be found in portal venous system.

Life cycle • Person become infected by contact with water containing infective cercaria. Cercaria attached to skin and are able to penetrate unbroken skin (can penetrate mucous membranes). • During penetration cercaria loss their tail and develop into schistosomules which migrate through SC tissue into blood vessels.

• In blood young flukes are carried • • through right side of heart to lung From lung most of schistosomules pass through left side of heart , enter abdominal aorta, and from there reach the portal (liver ) circulation. In blood vessels of the liver , young flukes reach maturity.



• • CLINICAL FEATURES : Swimmer's itch: may occur at site of cercarial penetration. In Schistosomiasis it is the eggs not adult which responsible for pathology. Eggs acquiring host antigens and protected from attack by host immune responses. Most eggs penetrate intestinal wall and excreted in stool with blood and mucus

• Trapped egg mature normally secreting antigens that produce strong immune response. • Egg it self do not damage body, cellular infiltration resultant from immune response that cause pathology associated with schistosomiasis






• Eggs lodged in mucosa lead to formation • • of granuloma- ulceration and thickening of bowel large granuloma lead to colonic and rectal polyp. Eggs reach liver through portal vein causing thickening of portal vessels =periportal fibrosis –in heavy infection lead to enlarged liver with fibrosis-portal hypertension –ascites and splenomegaly. Varicose v. in oesophagus –hematemesis Eggs in spinal cord , lung …. .







pathology & clinical picture of Schistosoma mansoni 1 -per patent period. 2 -egg deposition and extrusion. 3 -tissue proliferation.

1 -prepatent period: a-skin penetration: causing skin irritation N. B. from cercarial skin penetration to passage of eggs (adult stage) it take 5 -7 weeks. b- systemic symptoms (slight fever, muscle pain, --)


2 -Egg deposition and extrusion: Ø Ø Affect mainly large intestinal wall, liver and spleen. Intestinal wall: schistosomal dysentery (blood and mucus exudates in stool) , thickening and fibrosis of colon and rectum. Hepatomegaly: due to egg deposition. Splenomegaly: due to congestion Egg deposition: in other organs e. g. kidneys and spinal cord.

3 -Tissue proliferation & repair: Intestine: fibrosis, thickening and development of apillomata, loss of tone , fibrous constriction diarrhea fistulae. Periportal fibrosis , esophageal varices haematemesis , ascitis. Pulmonary complications: bronchopulmonary and cardiopulmonary lar disease ) cor pulmonale. CNS involvement.



Schistosoma hematobium


Pathology: • Swimmer's itch • Hematouria–eggs penetrate wall of • • bladder (blood in urine). Eggs trapped in wall of bladder causing granuloma. Many eggs calcified (sandy patch) Urinary infection–kidney damage – squamous cell carcinoma. Stones , nephrotic syndrome.





pathology& clinical picture of Schistosoma hematobium 1. Pre-patent period. 2. egg deposition and extrusion. 3. tissue proliferation.

1 -Prepatent period a. Skin penetrations : cause skin irritation N. B. From cercarial penetration to passage of eggs (adult stage) it take 1012 weeks. b. Systemic symptoms (slight fever, muscle pain…)


2 -Egg deposition and extrusion Ø Most eggs traped in sucbmucosa and muscularis of bladder. Initially painless terminal haematuria for months to years, then burning micturition. Cystoscopy shows hyperplasia and inflammation of lower bladder, initial papillomata.

3 - Tissue proliferation& repair: - Generalized hyperplasia and fibrosis of bladder, lower ureter, sandy patches, squamous cell carcinoma. b- Calaculi: obstructive uropathy leading to: -retrograde infection. -hydronephrosis and renal failure.


c- periportal fibrosis (eggs from v. of rectum and colon… portal vein …liver (PPF) d- lung involvement (eggs from hypogastric vein to- common iliac vein to –heart to lung )


Diagnosis of schistosomiasis: • Is by finding eggs depending on species in urine , feces, or rectal scraping.

Parasitological diagnosis : • Urinary schistosomiasis 1. urine : sedmentation, centrifugation, and filtration 2. Aspirate : bladder cystoscopy. 3. Biopsy : rectum protoscopy

• Intestinal schistosomiasis: Stool examination 1. Direct smear 2. Thick smear (kato method) 3. Concentration methods. Rectal mucosa : swab, aspirate and biopsy.

Ancillary investigation in schistosomiasis: • Endoscopy: papillomta • Radiological • - Ultrasound for liver periportal fibrosis. - X-ray calcification , obstructive uropathy Pulmonary changes e. g. cor pulmonale Serological tests: ELISA mainly survey method to detect: Ab : light or old infection Ag : in active infection.


Chemotherapy of schistosomiasis praziquantel.




Fasciola hepatica • Large fluke, 3 x 1. 5 cm • Causing fascioliasis • Common parasites of herbivores, cosmopolitan, mostly in sheep raising areas.

Immature egg

• _Fasciola-hepatica-Egg





Life cycle of Fasciola heptica

Life cycle Adult egg (in water) miracidium (pierce snail soft tissue multiply give sporocyst redia cercaria metacercaria (infective stage on water plant), Upon ingestion metacercaria burrows through duodenal wall liver parenchyma bile duct where it becomes adult.

Pathology Invasion of adult to biliary tree producing biliary obstruction and fibrosis. Eating raw liver infected with Faciola, adult worm attaches to pharyngeal mucosa causing pain, bleeding and edema.

Diagnosis Eggs in duodenal aspirate and stools. (Exclude spurious infection. ) Treatment : Bithionol Control: Avoid ingestion of infected plants.

- Slides: 77